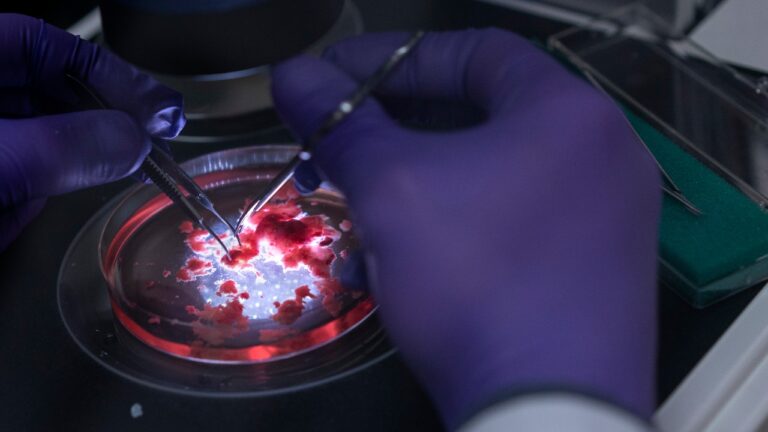
Kök hücre ile bir atılım daha: Göz yapıları geliştirildi

Bilim kurgu filmlerinde sıkça rastladığımız laser silahı teknolojisi nihayet gerçek oldu. ABD ordusu, lazer silahına sahip kara aracını tanıttı.
ABD, lazer silah prototipi ile şov yaptı
Sadece 24 ayda geliştirilen yeni teknoloji, Yönlendirilmiş Enerji-Manevra Kısa Menzilli Hava Savunması (DE M-SHORAD) adıyla tanıtıldı.

Stryker tarafından üretilen bir araca eklenen DE M-SHORAD, Oklahoma’da test edildi. ABD Donanması’nda da test edilen prototip lazer silahlar, askeri teknolojinin geleceği olarak görülüyor.

İsrail, Bayraktar’a karşı lazer silahı geliştirdi
Elbit Systems, İsrail Savunma Bakanlığı ile bir silah geliştirdi. Silahın Baykar Bayraktar TB2'ye karşı üretildiği düşünülüyor.Stryker ekibi, sistemi değerlendirmek ve gelecekteki sürümleri iyileştirmenin yollarını bulmak için gerçekçi tehditler içeren senaryolara tabi tutuldu.
Hipersonik, Yönlendirilmiş Enerji, Uzay ve Hızlı Edinme Direktörü Korgeneral L. Neil Thurgood, “Geliştirilen prototip üzerine çalışmalarımız devam ediyor. Askerlerin kullanımına sunmak için güvenli tasarlanması ve hedefe beklediğimiz gibi ulaşması için fazlaca mesai harcadık. Askerlerimize bu ilk operasyonel yeteneği vermenin zamanı geldi.” ifadelerini kullandı.
Geliştirme programının bir sonraki aşaması 2022 yılında gerçekleştirilecek. Test süreci tamamlandığında 4 adet lazer silahlı Stryker’ın ABD ordusuna teslim edilmesi bekleniyor.